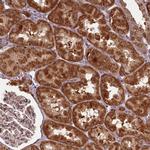
PCBP2 Antibody in Immunohistochemistry (Paraffin) (IHC (P))

Search
Invitrogen
PCBP2 Polyclonal Antibody
{{$productOrderCtrl.translations['antibody.pdp.commerceCard.promotion.promotions']}}
{{$productOrderCtrl.translations['antibody.pdp.commerceCard.promotion.viewpromo']}}
{{$productOrderCtrl.translations['antibody.pdp.commerceCard.promotion.promocode']}}: {{promo.promoCode}} {{promo.promoTitle}} {{promo.promoDescription}}. {{$productOrderCtrl.translations['antibody.pdp.commerceCard.promotion.learnmore']}}
产品信息
PA5-83415
种属反应
宿主/亚型
分类
类型
抗原
偶联物
形式
浓度
规格
纯化类型
保存液
内含物
保存条件
运输条件
RRID
产品详细信息
Immunogen sequence: IFAGGQDRYS TGSDSASFPH TTPSMCLNPD LEG
Highest antigen sequence indentity to the following orthologs: Rat - 100%, Mouse - 100%.
靶标信息
The protein encoded by this gene appears to be multifunctional. Along with PCBP-1 and hnRNPK, it is one of the major cellular poly(rC)-binding proteins. The encoded protein contains three K-homologous (KH) domains which may be involved in RNA binding. Together with PCBP-1, this protein also functions as a translational coactivator of poliovirus RNA via a sequence-specific interaction with stem-loop IV of the IRES, promoting poliovirus RNA replication by binding to its 5'-terminal cloverleaf structure. It has also been implicated in translational control of the 15-lipoxygenase mRNA, human papillomavirus type 16 L2 mRNA, and hepatitis A virus RNA. The encoded protein is also suggested to play a part in formation of a sequence-specific alpha-globin mRNP complex which is associated with alpha-globin mRNA stability. This multiexon structural mRNA is thought to be retrotransposed to generate PCBP-1, an intronless gene with functions similar to that of PCBP2. This gene and PCBP-1 have paralogous genes (PCBP3 and PCBP4) which are thought to have arisen as a result of duplication events of entire genes. This gene also has two processed pseudogenes (PCBP2P1 and PCBP2P2). Multiple transcript variants encoding different isoforms have been found for this gene.
仅用于科研。不用于诊断过程。未经明确授权不得转售。
篇参考文献 (0)
生物信息学
蛋白别名: Alpha CP2; Alpha-CP2; epididymis secretory sperm binding protein; Heterogeneous nuclear ribonucleoprotein E2; heterogenous nuclear ribonucleoprotein E2; hnRNP E2; MGC110998; Poly(rC)-binding protein 2; rCbinding protein 2; unnamed protein product
基因别名: hnRNP-E2; HNRNPE2; HNRPE2; PCBP2
UniProt ID: (Human) Q15366
Entrez Gene ID: (Human) 5094